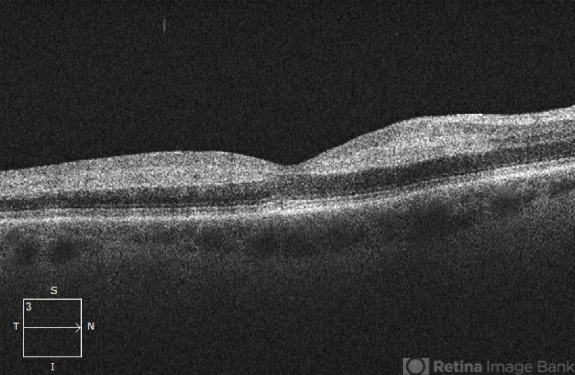

-
 By Christopher R. Adam, M.D.
By Christopher R. Adam, M.D.
Ophthalmic Consultants of Long Island - Uploaded on Dec 15, 2022.
- Last modified by Joshua Friedman on Dec 16, 2022.
- Rating
- Appears in
- Miscellaneous
- Condition/keywords
- BRAO, branch retinal artery occlusion (BRAO)
- Description
- OCT

Initializing download.
Initializing download.





---thumb.jpg/image-square;max$79,0.ImageHandler)
